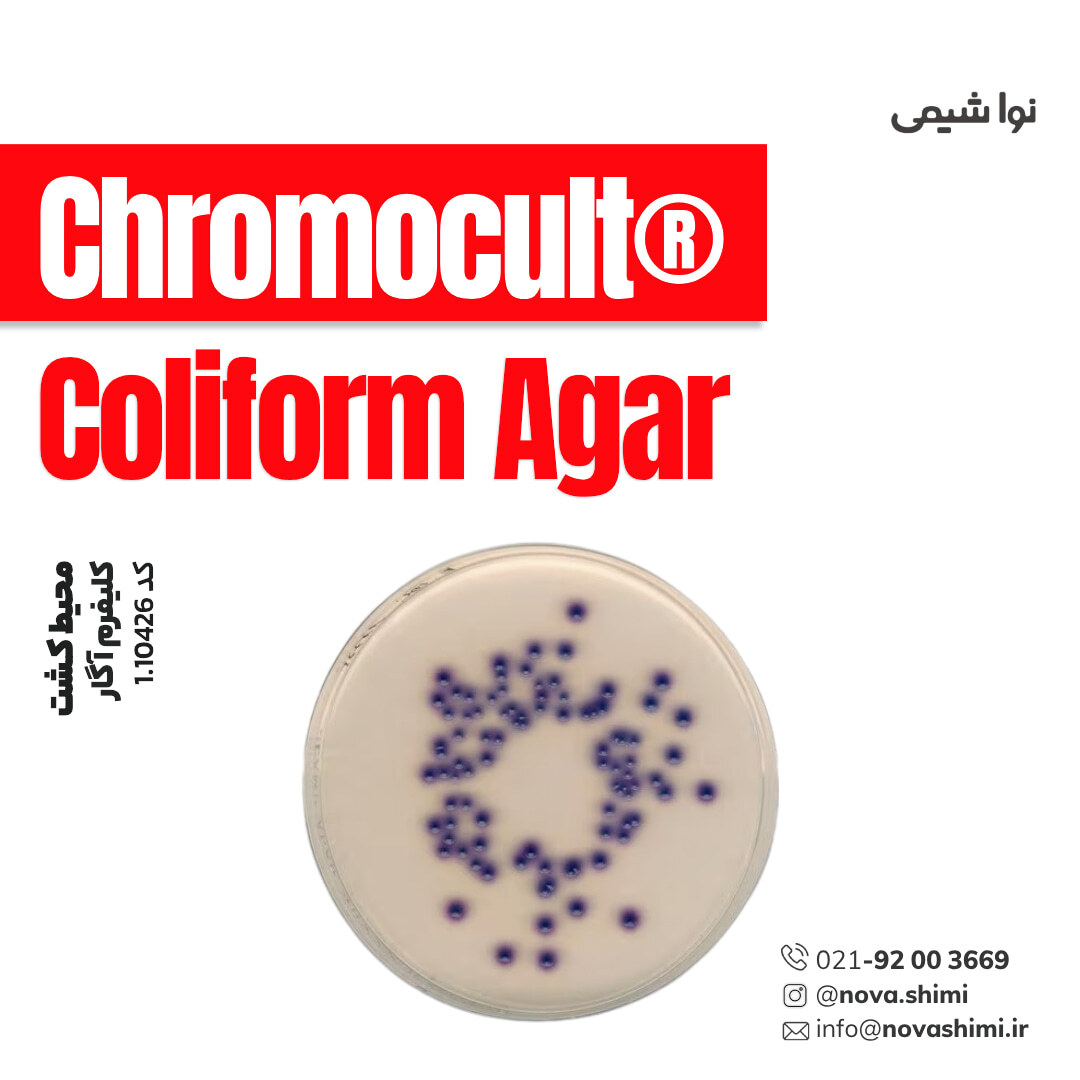
محیط کشت کلیفرم آگار (Coliform Agar)

محیط کشت کلیفرم آگار (Coliform Agar)
مشخصات فنی محیط کشت Coliform Agar:
1. برند: Merck Millipore
2. کاربرد: شناسایی سریع و تفکیک باکتریهای کلیفرم و E. coli در نمونههای آب و مواد غذایی است.
3. فرم فیزیکی: دانه ای(granular)
4. حجم بسته: 500 گرم
محیط کشت Coliform Agar چیست؟
کلریفرم آگار یک محیط افتراقی کروموژنیک برای شناسایی سریع و تفکیک باکتریهای کلیفرم و E. coli در نمونههای آب و مواد غذایی است. شرکت نُـواشیمی، به عنوان یکی از تامین کنندگان مواد آزمایشگاهی و محیط کشت برند مرک و سیگما آلدریچ، آماده ارائه خدمات فروش محیط کشت Coliform Agar مرک کد 1.10426 به شما عزیزان خواهد بود. برای دریافت اطلاعات فنی و استعلام قیمت محیط کشت کلیفرم آگار مرک، از طریق شماره 02192003669 با کارشناسان فروش نُـوا شیمی تماس حاصل فرمایید.
برای آشنایی بیشتر با ویژگیها و مشخصات محصول، میتوانید با کلیک روی هر عنوان، به توضیحات تکمیلی در زیرعنوانهای مربوطه دسترسی پیدا کنید.
مشخصات محصول (Product Specifications)
مشخصات فنی محیط کشت Coliform Agar مرک (Product Specifications)
در جدول زیر میتوانید مشخصات فنی محیط کشت کلریفرم آگار مرک را مشاهده کنید.
عنوان ویژگی | مشخصات |
|---|---|
نام محصول | Chromocult® Coliform Agar |
نام جایگزین | Coliform Agar، Chromogenic E. coli Agar، Chromogenic Coliform Agar |
برند/سازنده | Merck Millipore (ChromoCult®) |
کد محصول | 1.10426 |
CAS Number | 1473387-52-8 |
MDL Number | MFCD00008872 |
UNSPSC Code | 41106213 |
NACRES | NA.74 |
استانداردها / Agency | AOAC®, EPA، مطابق ISO 9308 |
کیفیت (Quality Level) | 200 |
استریلیتی | غیر استریل (Non-sterile) |
فرم فیزیکی | گرانول (granular) |
بستهبندی | 500 g pack |
کاربرد | میکروبیولوژی، صنایع غذایی و آشامیدنی |
مناسب برای | Coliforms و Escherichia coli |
سازگاری | قابل استفاده با E.coli / Coliform Selective-Supplement (کد 1.00898) |
برای مشاهده اطلاعات کامل محصول در سایت مرک و جزئیات کاربردی آن، بر روی Chromocult® Coliform Agar کلیک کنید. شرکت نُـوا شیمی، تأمینکننده انواع محیط کشت برندهای معتبر مانند مرک و سیگما آلدریچ است و امکان خرید آسان و مطمئن این محصولات آزمایشگاهی را برای شما فراهم میکند.
آنالیز و کیفیت (Analysis Note)
ویژگیهای آنالیزی و کیفیت (Analysis Note)
Appearance (ظاهر فیزیکی): گرانول خشک، همگن، رنگ زرد مایل به قهوهای
pH-value (در ۲۵°C، محلول ۲۶.۵ g/L در آب): بازه ۶.۶ تا ۷.۰
Form (فرم فیزیکی): گرانول آماده حلشدن (granular)
Selectivity (انتخابپذیری): کمانتخابی (Low-selective) با مهار جزئی باکتریهای گرم مثبت توسط Tergitol™ 7
Differential Indicators (شاخص افتراقی): دو سوبسترای کروموژنیک اختصاصی برای تمایز E. coli (آبی/بنفش) و Coliforms (صورتی/قرمز)
Target Organisms (میکروارگانیسمهای هدف): Escherichia coli و Coliforms
Carbon/Nutrient Sources (منابع غذایی): کمپلکسهای مغذی جهت رشد بهینه باکتریهای رودهای
Growth Promotion Test (تست رشد میکروبی): بازیابی ≥70% برای سویههای شاخص مطابق استاندارد DIN EN ISO 11133
Compatibility (سازگاری): قابل استفاده همراه با E.coli/Coliform Selective-Supplement – کد 1.00898
Suitability (کاربردپذیری): مناسب برای آب آشامیدنی، آب استخر ضدعفونی شده، آب تصفیهشده و غذاهای فرآوریشده
Storage Condition (شرایط نگهداری): محیط خشک با دمای ۱۵ تا ۲۵°C
Formulation Quality (سطح کیفیت): Quality Level 200
Sterility (استریلیتی): غیر استریل (non-sterile)
جدول راهنمای ویژگیهای آنالیزی محیط کشت Chromocult® Coliform Agar
| ویژگی | توضیحات | تحلیل و اهمیت |
|---|---|---|
| Appearance (ظاهر) | گرانول خشک، زرد تا زرد-قهوهای | یکنواختی رنگ و بافت نشانه پایداری مواد کروموژنیک و ترکیبات پایه است. |
| pH (۲۵°C، ۲۶.۵ g/L) | 6.6 – 7.0 | pH نزدیک خنثی بهترین شرایط را برای رشد و تمایز E. coli و Coliforms فراهم میکند. |
| Form (فرم فیزیکی) | گرانول آماده استفاده | آمادهسازی سریع، کاهش خطای عملیاتی و یکنواختی محلول نهایی را تضمین میکند. |
| Selectivity (انتخابپذیری) | مهار جزئی گرم مثبتها با Tergitol™ 7 | مانع رشد میکروارگانیسمهای مزاحم میشود بدون اینکه رشد باکتریهای هدف را مختل کند. |
| Differential Indicators (شاخص افتراقی) | سوبسترای کروموژنیک اختصاصی | جداسازی رنگی سریع: E. coli آبی/بنفش و Coliforms صورتی/قرمز. |
| Growth Promotion Test | بازیابی ≥70% برای سویههای مرجع ATCC | تضمین عملکرد استاندارد وفق ISO 11133 برای آزمونهای آب و غذا. |
| Target Organisms | Escherichia coli و Coliforms | پوشش دقیق باکتریهای شاخص آلودگی آب و مواد غذایی. |
| Carbon/Nutrient Sources | ترکیبات مغذی با قابلیت هضم آسان | رشد سریع و تولید کلونیهای واضح را تقویت میکند. |
| Compatibility | سازگار با مکمل انتخابی 1.00898 | افزایش حساسیت و کاهش رشد مزاحم برای آزمونهای دقیقتر. |
| Storage Condition | ۱۵–۲۵°C، خشک و محافظتشده | جلوگیری از تخریب مواد کروموژنیک و حفظ کیفیت محیط. |
| Suitability (کاربردپذیری) | مناسب برای آب آشامیدنی، استخر، خروجی تصفیهخانه و غذا | سازگاری کامل با آزمونهای ISO، EPA و AOAC برای کنترل بهداشت. |
خرید محیط کشت کلیفرم آگار مرک (Chromocult® Coliform Agar)
خرید محیط کشت گزیلور لیزین دِوکسی کولات (Chromocult® Coliform Agar) کد 1.10426
کلریفرم آگار کروموکالتی Chromocult® Coliform Agar یک محیط کشت کروموژنیک، گرانوله و کمانتخابی است که مطابق استانداردهای ISO 9308، EPA و AOAC برای شناسایی، تفکیک و شمارش همزمان باکتریهای کلریفرم و E. coli در نمونههای آب آشامیدنی، آب استخرهای ضدعفونیشده، خروجی تصفیهخانهها و مواد غذایی فرآوریشده طراحی شده است. این محیط با داشتن سوبستراهای کروموژنیک اختصاصی، امکان مشاهده مستقیم کلنیهای E. coli (به رنگ آبی–بنفش) و کلنیهای کلریفرم (صورتی–قرمز) را تنها طی ۲۴ ساعت فراهم میکند. وجود ماده بازدارنده Tergitol™ 7 باعث مهار باکتریهای گرممثبت میشود بدون اینکه رشد باکتریهای هدف را مختل کند. این ویژگیها Chromocult® را به یکی از دقیقترین و سریعترین محیطها برای پایش میکروبی منابع آب و صنایع غذایی تبدیل کرده است.
کمپانی مِرک (MERCK)
شرکت مرک (Merck KGaA) یکی از قدیمیترین و معتبرترین کمپانیهای علمی و فناوری در جهان است که در سال 1668 در آلمان تأسیس شد و امروزه بهعنوان پیشگام جهانی در حوزههای مواد شیمیایی آزمایشگاهی، بیوتکنولوژی و داروسازی شناخته میشود. بخش مواد آزمایشگاهی مرک، طیف گستردهای از مواد شیمیایی با گریدهای مختلف از جمله آنالیتیکال، ACS، HPLC، و Suprapur® را ارائه میدهد که برای تحقیقات علمی، کنترل کیفیت صنعتی، و مصارف آموزشی کاربرد دارند.
شرکت نُـوا شیمی، تامین کننده مواد آزمایشگاهی محیط کشت
شرکت نُـوا شیمی، با سابقهای درخشان در تامین مواد آزمایشگاهی، استاندارد ها و تجهیزات آزمایشگاه، با دسترسی گسترده به محصولات برندهای معتبر داخلی و بینالمللی، تامین نیازهای صنایع، آزمایشگاههای تحقیقاتی و داروسازی را با رویکردی مدرن و دقیق دنبال میکند. در صورت نیاز به استعلام قیمت محیط کشت کلیفرم آگار مرک کد 1.10426 یا سایر مواد آزمایشگاهی، استاندارد و رفرنسهای آزمایشگاهی کارشناسان ما از طریق خط ویژه 02192003669 آماده پاسخگویی و ارائه مشاوره تخصصی به شما خواهند بود.
کاربردهای محیط کشت Coliform Agar
مهمترین کاربردهای محیط کشت Coliform Agar:
در ادامه، کاربردهای محیط کشت کلیفرم آگار مرک را مطالعه خواهیم نمود:
1. شناسایی و شمارش همزمان E. coli و باکتریهای کلریفُرم
این محیط بهطور اختصاصی برای تشخیص تفکیکی (Differential) و شناسایی همزمان (Simultaneous Detection) باکتریهای Escherichia coli و سایر کلریفُرمها طراحی شده است.
به دلیل وجود سوبسترای کروموژنیک دوگانه، کلنیهای E. coli به رنگ آبی/بنفش و کلنیهای کلریفُرمها به رنگ صورتی/قرمز ظاهر میشوند.
این ویژگی آن را به یک محیط بسیار سریع و دقیق برای بررسی کیفیت آب و غذا تبدیل میکند.
2. کنترل کیفیت آب آشامیدنی مطابق استاندارد ISO 9308-1
Chromocult® Coliform Agar یکی از معدود محیطهایی است که برای نسخه جدید ISO 9308-1:2014 استفاده شده و مورد تأیید قرار گرفته است.
این استاندارد برای پایش آلودگی میکروبی آب آشامیدنی شهری و روستایی کاربرد دارد.
بهدلیل حساسیت بالا و تمایز رنگی واضح، نتایج در کمتر از ۲۴ ساعت قابل تفسیر است.
3. بررسی کیفیت آب استخرها و اسپای ضدعفونیشده
این محیط برای آبهای حاوی کلر یا محیطهای استخر و اسپا که نیاز به تستهای دقیق و حساس دارند، مناسب است.
حضور کلریفُرمها و E. coli در این نمونهها نشانه نقص در فرایندهای گندزدایی یا آلودگی ثانویه است.
4. کنترل کیفیت آب خروجی تصفیهخانهها
در تصفیهخانهها و واحدهای آبرسانی، این محیط برای:
پایش آب خروجی
تشخیص آلودگی ثانویه
تأیید کارایی فرایند کلرزنی، ازنزنی یا UV
استفاده میشود.
توانایی شمارش جداگانه E. coli و کلریفُرمها امکان تحلیل دقیق فرآیندهای تصفیه را فراهم میکند.
5. کنترل میکروبی غذاهای فرآوریشده (Food & Beverages)
این محیط در صنایع غذایی برای بررسی:
نوشیدنیها و آبمیوهها
غذاهای آماده
محصولات لبنی
کنسروها
محصولات گوشتی
استفاده میشود.
وجود کلریفُرمها در این مواد نشاندهنده آلودگی صلیبی، بهداشت نامناسب یا نقص در حرارتدهی است.
6. استفاده در کنترل کیفیت خطوط تولید و کارخانههای F&B
در کارخانجات صنایع غذایی، این محیط جهت بررسی:
نقاط بحرانی (CCP)
آب مصرفی خطوط
سطوح تماس با مواد غذایی
آب شستشو
استفاده میشود و آلودگیهای احتمالی را سریعا مشخص میکند.
7. آنالیز میکروبی نمونههای محیطی (Environmental Samples)
در آزمایشگاهها این محیط برای:
پایش سیستمهای آب صنعتی
برجهای خنککن
تجهیزات و مخازن نگهداری آب
استفاده میشود.
8. کاربردهای پژوهشی و دانشگاهی در حوزه میکروبیولوژی
به دلیل وضوح بسیار بالای کلونیها و افتراق رنگی، محیطی مناسب برای:
تحقیقات باکتریولوژی آب
مطالعات آلودگی میکروبی
آموزش دانشجویان میکروبیولوژی
است.
برای دریافت استعلام قیمت محیط کشت کلیفرم آگار مرک کد 1.10426، لطفا با شماره 02192003669 تماس حاصل فرمایید. کارشناسان ما آماده پاسخگویی به سوالات شما هستند.
نکات ایمنی
نکات ایمنی و نگهداری (Safety & Storage)
در ادامه نکات ایمنی استفاده از محیط کشت کلیفرم آگار مرک (Chromocult® Coliform Agar) برند مرک را مطالعه خواهیم نمود:
عنوان | نکات ایمنی خلاصه |
|---|---|
حفاظت فردی | استفاده از ماسک و دستکش برای جلوگیری از استنشاق و تماس با پوست و چشم |
فضای کار | آمادهسازی در محیط دارای تهویه مناسب یا زیر هود میکروبیولوژی |
نگهداری | دور از رطوبت و نور شدید، در ظرف دربدار |
استفاده از محلول آماده | فقط در ظروف استریل و خودداری از مصرف محیط آلوده یا تغییر رنگداده |
دفع پسماند | اتوکلاو و معدوم کردن باقیمانده محیط و نمونهها طبق پروتکل دفع پسماندهای بیولوژیک |
اگر به دنبال محیط کشت کلیفرم آگار (Coliform Agar) هستید، نُـوا شیمی همراهی مطمئن در مسیر تامین نیاز های شما خواهد بود. برای سفارش، دریافت مشاوره فنی و آگاهی از شرایط همکاری؛ از طریق شماره 02192003669 با تیم فروش در ارتباط باشید.
سوالات متداول (FAQ)
سوالات متداول درباره محیط کشت Coliform Agar:
1. کلریفرم آگار برای چه نوع باکتریهایی مناسب است؟
مناسب برای جداسازی و تشخیص Escherichia coli و باکتریهای کلریفرم است.
2. دمای نگهداری بهینه این محیط کشت چقدر است؟
در دمای ۱۵ تا ۲۵°C و محیط خشک نگهداری شود.
3. چطور میتوان رشد گونههای مورد نظر را تقویت کرد؟
با استفاده از مکمل انتخابی E.coli / Coliform Selective-Supplement (کد 1.00898) میتوان رشد و انتخابپذیری را افزایش داد.
4. چطور کلنیها بر اساس رنگ تفکیک میشوند؟
E. coli کلنیهای آبی تا بنفش و سایر کلریفرمها کلنیهای صورتی تا قرمز ایجاد میکنند.
5. آیا محیط برای دیگر باکتریها محدودیت دارد؟
رشد باکتریهای غیرکلریفرم و برخی باکتریهای گرم مثبت تا حدی مهار میشود.
6. زمان انکوباسیون چقدر است؟
معمولا ۲۱ ± ۳ ساعت در دمای ۳۶ ± ۲ °C.

هنوز نظری ثبت نشده
اولین نفری باشید که نظر میدهید
ثبت نظر